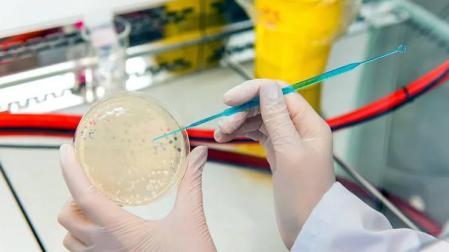
Un cultivo de un investigador.

La Aceleradora HEALTH se pone en marcha con seis proyectos en el ámbito de la salud
Cuando finalice el proceso de aceleración se premiará con 8.000 euros la mejor de las iniciativas

Publicado el 05/10/2021 a las 11:53
La Aceleradora HEALTH, impulsada por el Departamento de Universidad, Innovación y Transformación Digital, a través de la sociedad pública Centro Europeo de Empresas e Innovación de Navarra (CEIN), ha iniciado su andadura con seis iniciativas empresariales en el ámbito de la salud.
El propósito de este programa es apoyar a personas emprendedoras con proyectos innovadores en el sector salud hasta su creación como empresa, así como a iniciativas ya en marcha con un máximo de un año en el mercado.
Los promotores de los proyectos participantes trabajan en la validación de su idea y en el desarrollo de su modelo de negocio a través de un itinerario formativo adaptado a la fase en la que se encuentran. Igualmente, cuentan con tutorías individualizadas, acompañadas de consultoría especializada por parte de profesionales en activo y con experiencia de mercado.
Entre otros ámbitos, la aceleradora profundiza en los modelos de negocio en salud, el marco legal y regulatorio del sector, la propiedad industrial, las modalidades de financiación y el plan de negocio.
Además, las propuestas que superen el proceso podrán presentarse ante un jurado, que determinará el premio al “Mejor proyecto del año 2021 de la Aceleradora HEALTH”, dotado con 8.000 euros que irán destinados a la puesta en marcha de la iniciativa.
PROYECTOS DE LA ACELERADORA HEALTH
Los proyectos que participan en este momento en la aceleradora son los siguientes:
- Test a domicilio de fertilidad. Test focalizados en el ámbito de la fertilidad para mujeres que deseen conocer sus niveles hormonales. En este caso, los clientes son mujeres de 35 a 45 años que están buscando quedarse embarazadas pero que presentan problemas de fertilidad. El proyecto ofrece un sistema de recolección de muestra en el hogar de tal forma que la mujer puede tomarla en el horario que decida. No es necesario acudir físicamente a ningún laboratorio ni centro médico.
- Dispositivo de formación y entrenamiento para paradas cardiacas. AED Training Box es una herramienta de aprendizaje, enseñanza y entrenamiento en reanimación cardiopulmonar (RCP) y uso del desfibrilador. Los simuladores actuales son de alto coste, mientras que este dispositivo es asequible y facilita que se pueda llegar a colectivos más amplios. AED Training Box es también una herramienta de evaluación para el instructor y para el alumno y emplea la filosofía MAKE, que combina una caja de cartón con una aplicación móvil.
- Coach integral de salud. Sendo Health es un coach integral de salud con app para pacientes y back profesional para médicos (totalmente integrados). El sistema programa actividad física y nutrición y ayuda al paciente a gestionar el sueño y el estrés con algoritmos específicos asociados a patologías concretas.
- Creación y diseño de dispositivos médicos. Vidorreta Medical Innovation es una empresa de base tecnológica dedicada a la creación y diseño de dispositivos médicos en las fases de TRL1 a TRL 6 mediante un proceso de innovación propio que combina medicina, ingeniería, investigación y diseño. Está especializada en productos de base electromecánica y “wearables” (portable) de gran potencial innovador y un alto grado de valor añadido.
- Plataforma de monitorización remota de pacientes. Vitio ayuda a los centros y profesionales sanitarios a controlar a sus pacientes de forma remota con dispositivos de diagnóstico avanzados. También ha desarrollado Vitemp, un termómetro inteligente que monitoriza la temperatura corporal de forma remota las 24 horas del día, los 7 días de la semana.
- Inteligencia artificial (IA) y neoplasias gastrointestinales. Se trata de una aplicación de la Inteligencia Artificial (IA) para la optimización del tratamiento endoscópico de las neoplasias gastrointestinales. Predicción y anticipación de potenciales complicaciones (hemorragia y perforación).
PROGRAMA CEIN HEALTH
La Aceleradora HEALTH forma parte del programa CEIN HEALTH, que facilita servicios especializados para el fomento, la aceleración y el escalado de iniciativas de innovación y emprendimiento en salud.
Entre otras acciones, se ha convocado un concurso de ideas de negocio en el sector de la salud, se ha puesto en marcha la Academia de Innovación Sanitaria (dirigida a profesionales del sistema de salud navarro) y se celebran masterclass sectoriales.
Además, cinco startups que operan en el sector participan en el programa HEALTH ScaleUp, orientado a impulsar su crecimiento y escalado.